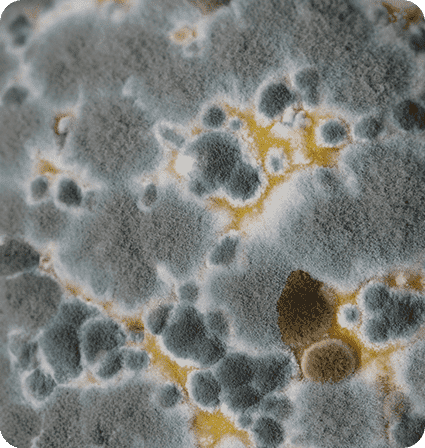
A close up of the surface of an ocean

What We Do
We specialize in the expert removal and remediation of mold and mildew problems in both homes and businesses. Our thorough mold damage inspections utilize advanced thermal camera technology to accurately identify moisture issues that may lead to mold growth. We offer comprehensive air quality testing services. Additionally, as licensed general contractors, we provide complete mold damage repairs, restoring your property to its original condition with the highest standards of quality and care.

Mold Removal & Remediation Process
Mold Inspection
Utilizing advanced thermal camera technology, we conduct thorough inspections to identify and locate moisture issues affecting your property. This complimentary service aims to protect you from the harmful effects of mold and water damage. Owners receive a free inspection, while tenants or properties in escrow are charged $250, including a comprehensive inspection report.
Containment Barrier
We establish containment barriers with negative air pressure to isolate affected areas. Our hospital-grade air filtration systems ensure cleaner air inside and outside the containment zone. Trust us to maintain a safe and clean environment throughout the remediation process.
Mold Removal
Once containment barriers are in place, our team safely removes mold-damaged materials from your property. We adhere to the latest regulations and guidelines for mold disposal to mitigate health risks associated with mold damage effectively.
Mold Damage Repairs
As a licensed general contractor, Kauai Mold Water Fire handles all necessary repairs your property may require. With extensive experience in restoration and construction, we provide comprehensive solutions for mold damage repairs of any scale. Trust us to restore your property to its pre-damage condition with expertise and care.
Contact For 24/7 Emergency Services
Are you facing a mold emergency? Don't hesitate to reach out. Our team at Kauai Mold Water Fire is here 24/7 for you. Your safety and peace of mind are our top priorities.